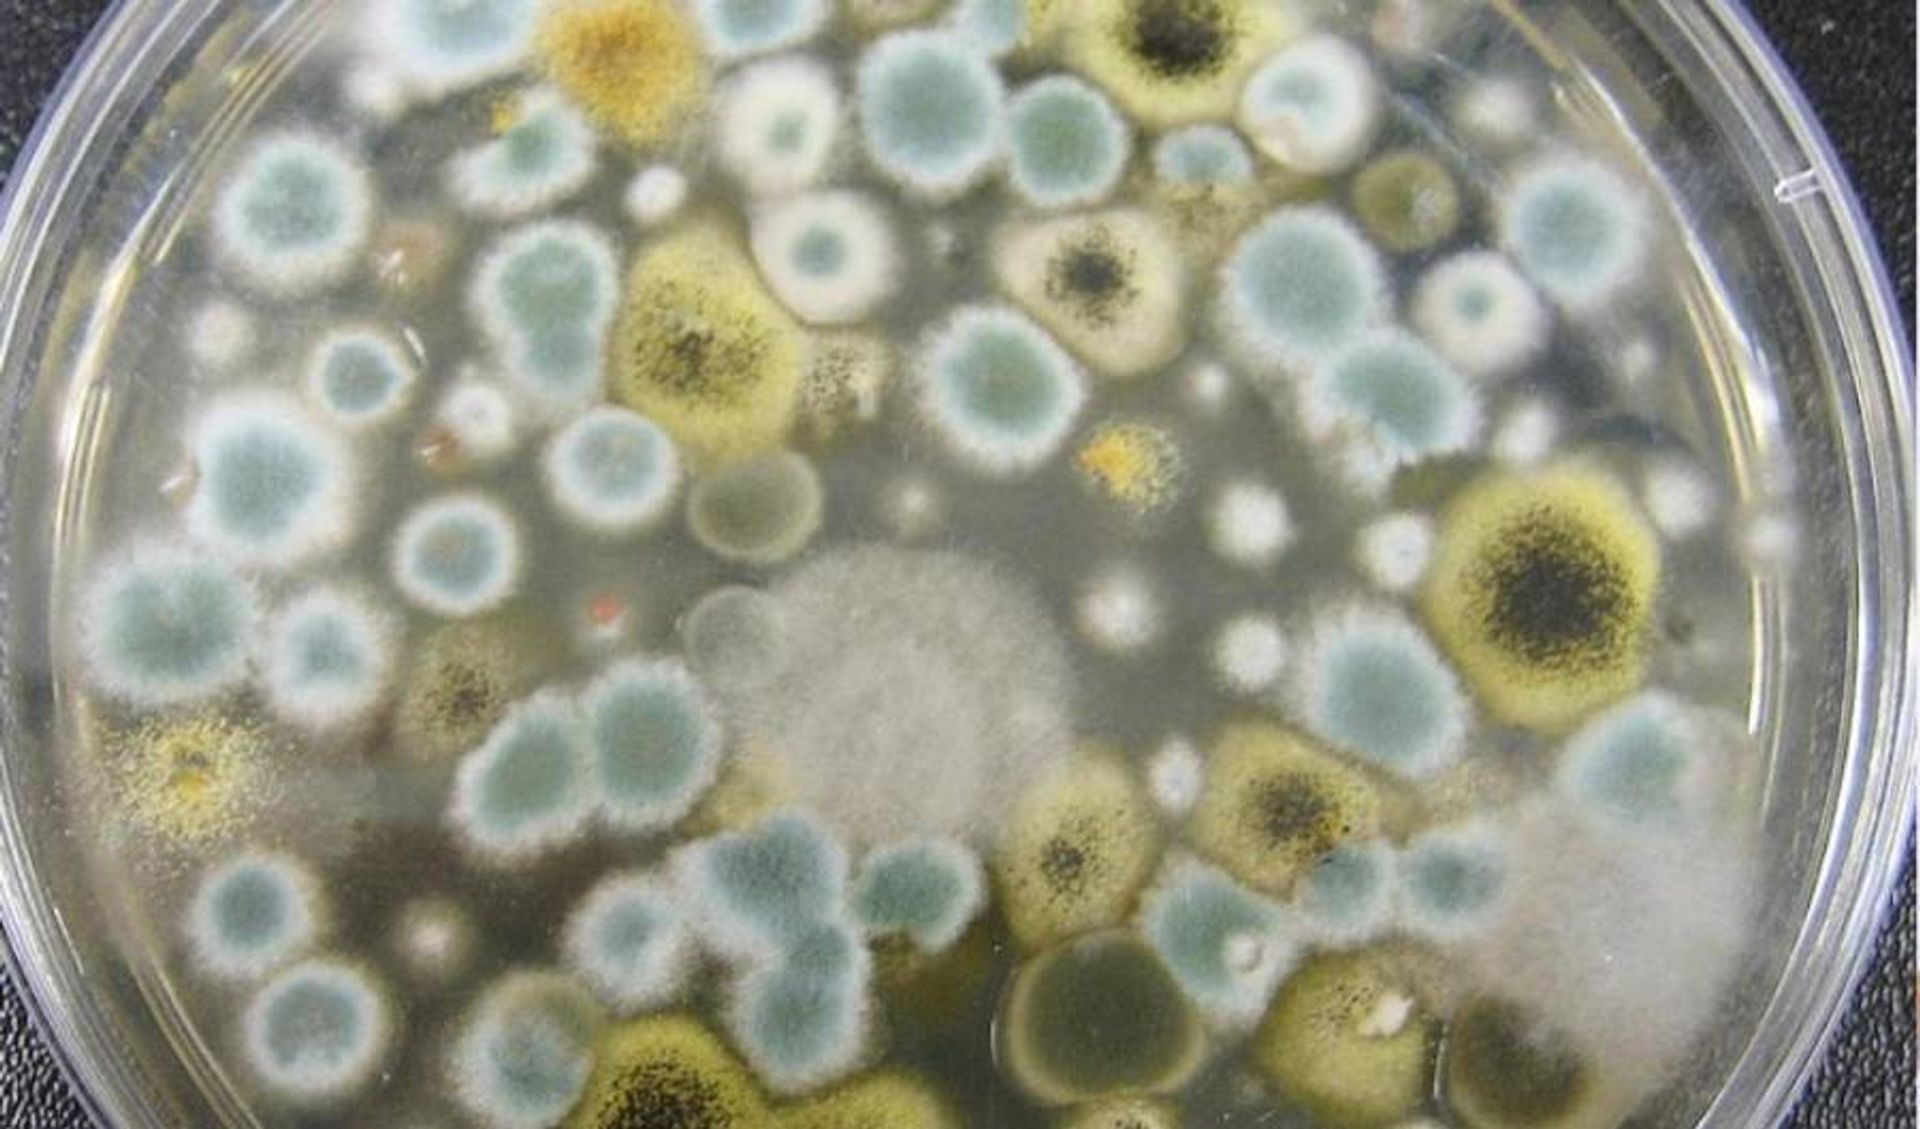
Plagas y Enfermedades en el Cultivo de Hongos: Guía Completa de Identificación, Control y Prevención

Tipos de Hongos Alucinógenos en Colombia: Guía Completa de Especies y Contexto Legal
Guía exhaustiva sobre los hongos psilocibios en Colombia: identificación de especies (Psilocybe cubensis, semilanceata, etc.), análisis legal actual (2025), usos tradicionales y reducción de riesgos.








![Reishi (Ganoderma): El Hongo de la Inmortalidad [Guía Científica]](/_astro/ganoderma-lucidum.yd68tXRN_Z2eNeU0.jpeg)









![Industria de Hongos en Colombia: Reporte de Mercado y Oportunidades [2025]](/_astro/cultivo-de-hongos-1-1024x574.MJ1gFs1g_Z2vgG45.jpeg)